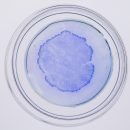

Microuniverse Glass #1 est un set de bactéries préservées dans des assiettes en verre.
Microuniverse Glass #12
€ 650,00–€ 5500,00 HT
Tal Danino est un artiste interdisciplinaire qui explore le domaine émergent de la biologie synthétique. Son travail transforme les micro-organismes vivants comme les bactéries et les cellules cancéreuses en œuvres de bio-art à travers différents médias. Originaire de Los Angeles, Tal a obtenu un diplômes en physique, mathématiques et chimie à l’UCLA et un doctorat en bioingénierie à l’UCSD. Il a fait ses recherches postdoctorales au MIT et est boursier TED. Il est actuellement professeur adjoint à l’Université Columbia. En savoir plus
Information Complémentaire
| Poids | 3 kg |
|---|---|
| Dimensions | 30 x 2 x 30 cm |
| Collection du commissaire : | Doo Eun Choi |
| Artiste | Tal Danino |
| Année | 2017 |
| Pays | USA |
| Technique | Technique Mixte |
| Edition | Oeuvre unique |
| Certificat d'authenticité | Oui |